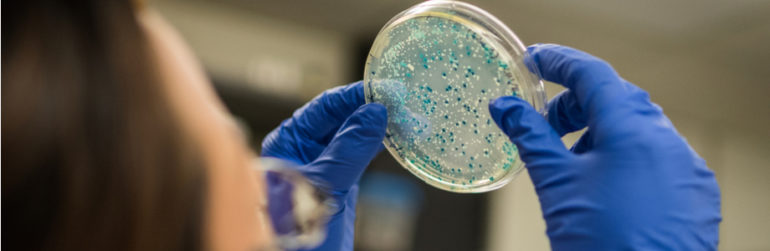

Une étude récente souligne l’émergence d’une salmonelle devenue résistante à presque tous les antibiotiques, et identifie la volaille comme le principal vecteur de la souche.
Les bactéries de type Salmonella représentent une des premières causes d’infections alimentaires. Les chercheurs français du Centre national de référence des Salmonella à l’Institut Pasteur (CNR) et de l’Institut de veille sanitaire ont détecté, dès 2002, l’émergence d’une bactérie appelée «Salmonella Kentucky». Elle présentait en effet des résistances à de nombreux antibiotiques, et notamment aux fluoroquinolones, habituellement utilisés pour les infections sévères à Salmonella.
Les chercheurs français se sont associés avec plusieurs institutions de surveillance et de recherche internationales et ont constaté une nette augmentation du nombre de contaminations dès 2006, ainsi que leur élargissement géographique. De 500 cas en 2002 en France, au Royaume-Uni et au Danemark, on est passé à 270 cas recensés uniquement en France en 2009.
En se penchant sur l’étude génétique des souches bactériennes des différentes zones de contamination, les chercheurs ont décrypté la chronologie d’apparition de la bactérie et ses mécanismes de résistances. C’est en Egypte qu’ils attribuent l’origine d’apparition des résistances aux antibiotiques, probablement par l’intermédiaire des élevages aquacoles. L’épidémie actuelle s’expliquerait par la propagation de la bactérie en Afrique dans la filière volaille.
La Salmonella Kentucky semble commencer à s’implanter en Europe, multipliant le risque d’une propagation à grande échelle. Cette étude rappelle le risque de l’utilisation non réglementée d’antibiotiques dans les élevages…